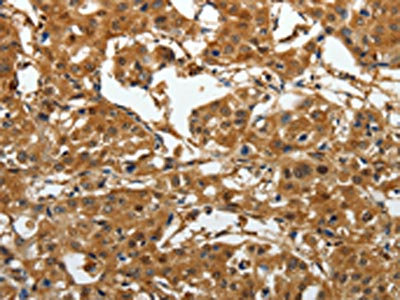

AKAP12 Antibody
-
中文名稱:AKAP12兔多克隆抗體
-
貨號(hào):CSB-PA610964
-
規(guī)格:¥1100
-
圖片:
-
The image on the left is immunohistochemistry of paraffin-embedded Human brain tissue using CSB-PA610964(AKAP12 Antibody) at dilution 1/40, on the right is treated with synthetic peptide. (Original magnification: ×200)
-
The image on the left is immunohistochemistry of paraffin-embedded Human lung cancer tissue using CSB-PA610964(AKAP12 Antibody) at dilution 1/40, on the right is treated with synthetic peptide. (Original magnification: ×200)
-
-
其他:
產(chǎn)品詳情
-
Uniprot No.:
-
基因名:AKAP12
-
別名:A kinase (PRKA) anchor protein (gravin) 12 antibody; A kinase Anchor Protein 12 antibody; A kinase anchor protein 250kDa antibody; A-kinase anchor protein 12 antibody; A-kinase anchor protein 250 kDa antibody; AKA12_HUMAN antibody; AKAP 12 antibody; AKAP 250 antibody; AKAP-12 antibody; Akap12 antibody; AKAP250 antibody; DKFZp686M0430 antibody; DKFZp686O0331 antibody; FLJ20945 antibody; FLJ97621 antibody; Gercelin antibody; Gravin antibody; Kinase scaffold protein gravin antibody; Myasthenia gravis autoantigen antibody; Myasthenia gravis autoantigen gravin antibody; OTTHUMP00000017426 antibody; OTTHUMP00000017427 antibody; Src-Suppressed C Kinase Substrate antibody; Srcs5 antibody; SSeCKS antibody; Tsga12 antibody
-
宿主:Rabbit
-
反應(yīng)種屬:Human
-
免疫原:Synthetic peptide of Human AKAP12
-
免疫原種屬:Homo sapiens (Human)
-
標(biāo)記方式:Non-conjugated
-
抗體亞型:IgG
-
純化方式:Antigen affinity purification
-
濃度:It differs from different batches. Please contact us to confirm it.
-
保存緩沖液:-20°C, pH7.4 PBS, 0.05% NaN3, 40% Glycerol
-
產(chǎn)品提供形式:Liquid
-
應(yīng)用范圍:ELISA,IHC
-
推薦稀釋比:
Application Recommended Dilution ELISA 1:3000-1:10000 IHC 1:50-1:200 -
Protocols:
-
儲(chǔ)存條件:Upon receipt, store at -20°C or -80°C. Avoid repeated freeze.
-
貨期:Basically, we can dispatch the products out in 1-3 working days after receiving your orders. Delivery time maybe differs from different purchasing way or location, please kindly consult your local distributors for specific delivery time.
-
用途:For Research Use Only. Not for use in diagnostic or therapeutic procedures.
相關(guān)產(chǎn)品
靶點(diǎn)詳情
-
功能:Anchoring protein that mediates the subcellular compartmentation of protein kinase A (PKA) and protein kinase C (PKC).
-
基因功能參考文獻(xiàn):
- Low AKAP12 expression is associated with high-grade meningiomas. PMID: 29391485
- There is a positive association between the expression of AKAP12 and Semaphorin 3F in prostate cancer, suggesting that the activation of Semaphorin 3F by AKAP12 may be involved in prostate cancer progression and metastasis. PMID: 28698137
- A critical role for AKAP12 as an UV-inducible scaffold for PKA-mediated ATR phosphorylation. PMID: 27683220
- the AKAP12a promoter shows high DNA methylation levels in juvenile myelomonocytic leukemia, which go along with reduced AKAP12a mRNA expression levels PMID: 26891149
- MiR-103 regulates hepatocellular carcinoma growth by targeting AKAP12 PMID: 26646106
- results suggest that the association between the 6q25.1 locus and breast cancer risk may be mediated through single nucleotide polymorphisms that regulate expressions of the AKAP12 gene. PMID: 26645718
- The authors propose that Gravin-mediated recruitment of Aurora A and Plk1 to the mother (oldest) spindle pole contributes to the fidelity of symmetric cell division. PMID: 26406118
- The SSeCKS, a major Lipopolysaccharide (LPS) response protein, has been involved in regulating astrocyte activation via production of proinflammatory factor in CNS inflammation. PMID: 26428665
- Elevated expression of AKAP12 is characteristic of paclitaxel-resistant high-grade serous ovarian cancer cells, and a prognostic and predictive marker for poor overall survival in SOC patients. PMID: 25748058
- The enrichment of activated Cdc42 in SSeCKS-null leading edge filopodia correlated with recruitment of the Cdc42-specific guanine nucleotide exchange factor, Frabin. PMID: 25356636
- AKAP12 scaffolding protein mediates meningeal reconstruction after central nervous system injury PMID: 25229625
- PKA compartmentalization via AKAP220 and AKAP12 contributes to endothelial barrier regulation. PMID: 25188285
- This study showed that AKAP12,CAMK2D and a molecular pathway(cyclic amp)association to outcome of depressive during citalopram treatment. PMID: 24986638
- AKAP12 variant 2 hypoxic induction shifts PKA-mediated protein phosphorylation to enhance migration and metastasis of melanoma cells PMID: 25792458
- AKAP12 expression was positive in 82.2% of tumors in a cohort with colorectal adenocarcinoma. AKAP12 expression was unrelated to p53 or Bcl-2 expression. PMID: 24870731
- Receptor-mediated Ca2+ and PKC signaling triggers the loss of cortical PKA compartmentalization through the redistribution of gravin. PMID: 23838009
- High AKAP12 expression is associated with colorectal cancer. PMID: 24065476
- AKAP12 is differentially expressed in human astrocytomas showing high expression in pilocytic but low expression in diffuse astrocytomas of all WHO-grades. further, epigenetic mechanisms are involved in silencing AKAP12 in diffuse astrocytomas PMID: 24042196
- Gravin gene expression is decreased in acute myeloid leukemia and correlates with poor prognosis. PMID: 23543478
- Data suggest a model in which SSeCKS suppresses oncogenic motility by sequestering Src to caveolin-rich lipid rafts, thereby disengaging Src from FAK-associated adhesion and signaling complexes. PMID: 22710722
- demonstrated for the first time that AKAP12 tumor/angiogenesis suppressor gene is an epigenetic target of HDAC7 PMID: 22584896
- It defines a role for Gravin as a temporal organizer of phosphorylation-dependent protein-protein interactions during mitosis. PMID: 23063527
- The results demonstrate that AKAP12 may play an important role in tumor growth suppression and the survival of human colorectal cancer. PMID: 21918680
- PKC-mediated remodeling of the actin cytoskeleton is likely regulated by the ability of SSeCKS to control PKC signaling and activity through a direct scaffolding function PMID: 21903576
- AKAP12 is involved in the regulation of endothelial cell migration through the inhibitory regulation of MMP-9 expression in tumor cells. PMID: 21461577
- AKAP12 promoter methylation is a frequent event in human prostate cancer. PMID: 21310466
- SERPINB5 and AKAP12 may have a role in increased metastasis in pancreatic ductal adenocarcinoma PMID: 20939879
- Data show that AKAP12 methylation represents a potential molecular biomarker for predicting the malignancy of colorectal cancer. PMID: 20364105
- AKAP12alpha promoter methylation is associated with lung cancer. PMID: 21115911
- In addition to genetic alterations, epigenetic mechanisms are responsible for the reduction of the tumor suppressor gene AKAP12 in human hepatocarcinogenesis. PMID: 20979053
- Findings suggest that SSeCKS suppresses metastatic motility by disengaging activated Src and then inhibiting the PKC-Raf/MEK/ERK pathways controlling matrix metalloproteinase-2 expression and podosome formation. PMID: 20018890
- gravin provides a dynamic platform for the localization for kinases during neuronal development PMID: 12857743
- AKAP250 acts as a scaffold that binds protein kinase A (PKA), protein kinase C and protein phosphatases, associating reversibly with the beta(2)-adrenergic receptor. PMID: 14657015
- AKAP12A may function as an important negative regulator of the survival pathway in human gastric cancer. PMID: 15258566
- AKAP12alpha belongs to a novel class of atypical SRF-dependent target genes PMID: 15590635
- AKAP12 localization is regulated by a hierarchy of targeting domains and the localization of AKAP12-assembled signaling complexes may be dynamically regulated PMID: 15923193
- Results suggest that gravin maintains a signaling complex that includes protein kinase A and phosphodiesterase 4D. PMID: 16642035
- Membrane binding of gravin, and thus function, can be reversed by calcium/calmodulin, which binds to the membrane and causes translocation of gravin from membrane to cytoplasm. PMID: 16762919
- We conclude that LPA-dependent increased level of cAMP in senescent human diploid fibroblasts is associated with increases in Gravin levels resulting in its increased binding with and activation of calcium-dependent PKC alpha/beta and AC4/6. PMID: 17081159
- The Src-binding peptide-(1-51) of gravin behaves as a dominant-negative for AKAP gravin regulation of beta2-adrenergic receptor resensitization/recycling PMID: 17200117
- Results suggest that AKAP12 may play an important role in tumor growth suppression by inducing apoptosis with the regulation of multiple molecules in the cell cycle progression. PMID: 17442483
- AKAP12 may induce BRB formation through antiangiogenesis and barriergenesis in developing human eye and defects in this mechanism can lead to loss of tight junction proteins and contribute to development of retinal pathologies such as retinoblastoma. PMID: 17442832
- The Gravin expression was found to be decreased in samples of acute leukaemia and was associated with an inferior overall survival. PMID: 17577780
- Hypermethylation of the AKAP12 promoter is associated esophageal carcinoma. PMID: 18199717
- AKAP12 in astrocytes induces barrier functions in human endothelial cells through protein kinase Czeta. PMID: 18397319
- These findings implicate AKAP12 in the regulation of cytokinesis progression, and suggest a novel role for AKAP12 tumor suppressor. PMID: 18554502
- Results suggest that AKAP12A may activate SREBP-2 by increasing cholesterol efflux, and is a novel regulator of cellular cholesterol metabolism. PMID: 18579430
- AKAP12 docks to the beta2-adrenergic receptor in response to agonist stimulation, later internalizes with agonist-induced receptors, and finally dissociates from the recycled, cell membrane-bound receptor. PMID: 18950703
- Data show that PKC activation resulted in redistribution of gravin and PKA constructs to the same subcellular site, and suggest that this response to PKC activity may mediate PKC dependent control of PKA activity. PMID: 19210988
- Data revealed that six polymorphisms of F10, PITRM1, PCSK2, JPH3, MYO7B, and AKAP12 were related (P<0.05) to the prevalence of chronic kidney disease. PMID: 19724895
顯示更多
收起更多
-
亞細(xì)胞定位:Cytoplasm, cell cortex. Cytoplasm, cytoskeleton. Membrane; Lipid-anchor. Note=May be part of the cortical cytoskeleton.
-
組織特異性:Expressed in endothelial cells, cultured fibroblasts and osteosarcoma, but not in platelets, leukocytes, monocytic cell lines or peripherical blood cells.
-
數(shù)據(jù)庫(kù)鏈接:
Most popular with customers
-
-
YWHAB Recombinant Monoclonal Antibody
Applications: ELISA, WB, IHC, IF, FC
Species Reactivity: Human, Mouse, Rat
-
-
-
-
-
-